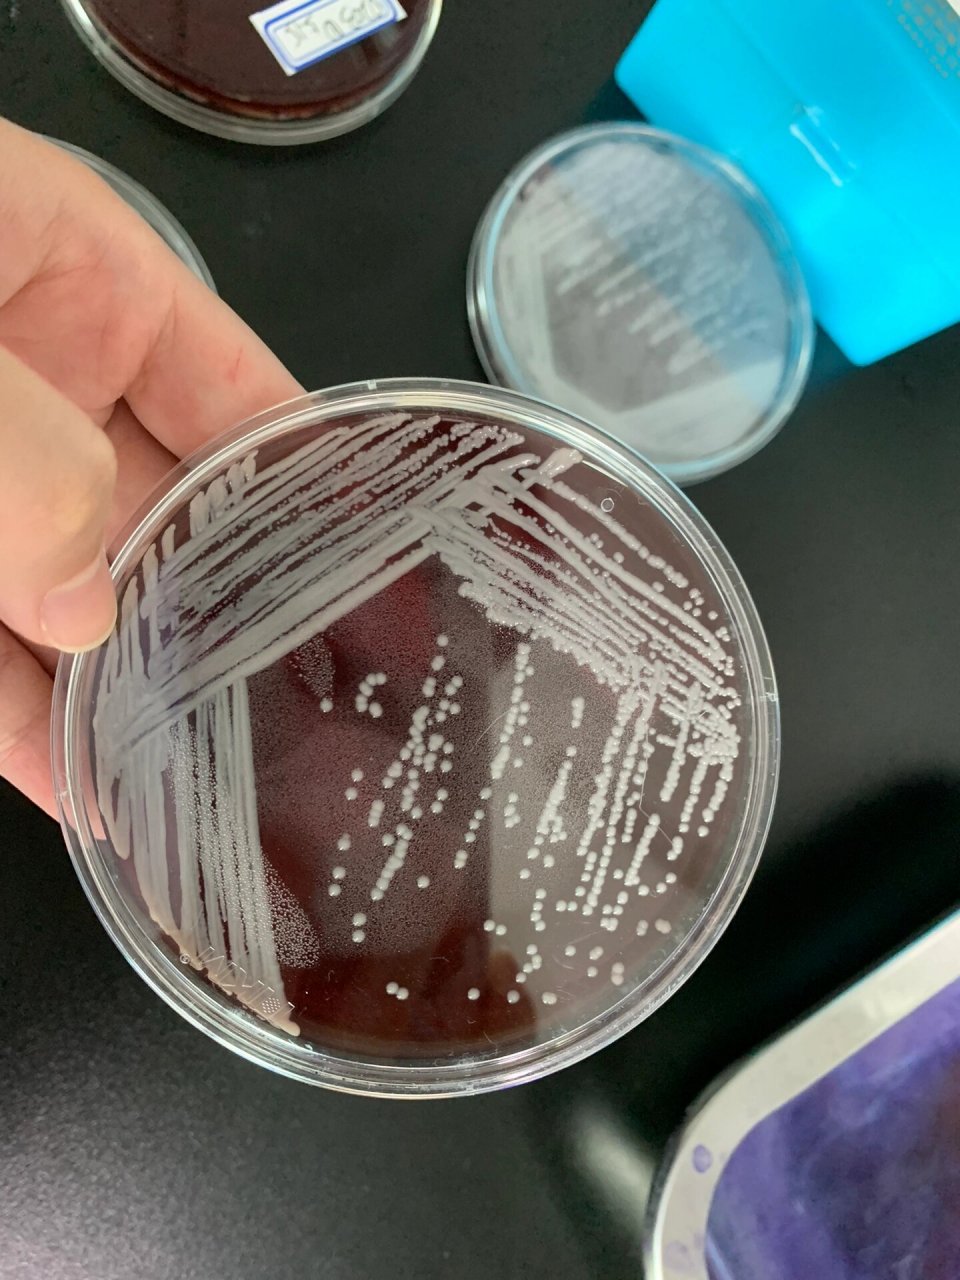

2025-04-08 17:38:58 阅读量:324
操作前准备:
1. 将接种环、酒精灯、打火机、无菌平板、酒精棉球、镊子、洁净烧杯放入超净工作台。
2. 打开紫外灯,灭菌30分钟。
3. 取菌种放入超净工作台。
4. 操作者直立坐于操作台前,打开操作台玻璃,调整合适高度,双手可顺利出入即可,不可过高。
操作步骤:
1. 双手及操作台面消毒
用镊子取酒精棉球擦拭双手,并在超净工作台门口处擦拭出一个与肩同宽的正方形区域,作为操作区域。
将用过的酒精棉球放入烧杯中。
2. 物品摆放
将所需物品有序摆放在操作区域内,确保操作过程中取用方便。
3. 点燃酒精灯
打开酒精灯盖,将盖子扣放在远离操作区的台面上。
点燃酒精灯,酒精灯周围35 cm范围内为无菌区。
4. 灼烧接种环
右手持接种环,将金属丝部分置于酒精灯外焰中灼烧至红透。
倾斜接种环,灼烧金属杆部分,确保金属丝与金属杆连接处充分灼烧。
5. 取菌种
左手持菌种试管的底部,将试管口置于火焰的无菌区。
用右手小指打开试管塞,将接种环的金属丝再次灼烧至红透。
将接种环伸入试管内,稍作冷却后,轻轻取一环菌种,注意不要划破培养基。
取出接种环时,避免触碰试管壁。
将试管塞在火焰外焰处灼烧一圈后塞回试管,注意避免烫伤。
6. 平板划线
左手取一个无菌平板,用拇指和食指控制皿盖,其余手指控制皿底。
打开皿盖,使开口角度小于30°。
将接种环上的菌种按划线法接种:
一区法:连续划线,线的边缘应划至培养皿内缘,线要紧密但不相连。
三区或四区法:每划完一区后,灼烧接种环,后一区与前区首尾相连但不重叠。
7. 培养
将划线完毕的平板倒置放入恒温培养箱中培养。
8. 整理台面
操作结束后,将实验物品放回原处。
清理实验产生的垃圾,带出超净台并丢弃至垃圾桶。
9. 结果观察
72小时后观察平板:
应无杂菌污染,若菌落不在划线上则为杂菌。
划线应平直且接近平板边缘,线间紧密但不重叠。
应有较多单菌落,至少10个以上为合格。
注意事项:
操作过程中始终保持无菌意识,避免污染。
灼烧接种环和试管塞时注意安全,避免烫伤。
划线时动作轻柔,确保菌种均匀分布。
培养过程中保持平板倒置,防止冷凝水滴落影响菌落生长。
接种环刚灼烧灭菌后,温度较高,需冷却后再接触菌种和划线,避免菌种大量死亡、培养基融化。
通过以上步骤,可有效完成微生物平板划线操作,确保实验结果的准确性和可靠性。